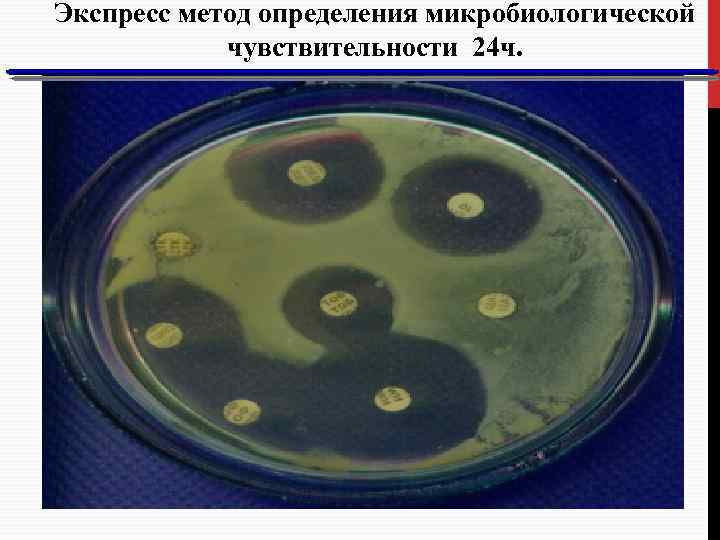
Экспресс метод определения микробиологической чувствительности 24 ч.

Лекция для кур сантов сепсис (новая) 2014.pot.pptx
- Количество слайдов: 77

ОСОБЕННОСТИ ДИАГНОСТИКИ И ЛЕЧЕНИЯ СОВРЕМЕННОГО СЕПСИСА В АКУШЕРСТВЕ ПРОФ. ПОСОХОВА С. П. ОНМУ

СЕПСИС Сепсис - это фаза развития любого инфекционного заболевания с различной локализацией, вызванного Условно патогенными микроорганизмами, в основе которого лежит системная воспалительная реакция. • Сепсис – это не воспаление. Это чрезмерная активность иммунной системы. Наша защита от микробов так сильна, что она страшнее самих возбудителей. Сепсис - общее инфекционное заболевание, возникающее в условиях иммунной недостаточности организма при постоянном или периодическом поступлении в кровяное русло микроорганизмов и их токсинов из местного очага инфекции. Moss M, Martin GS. A global perspective on the epidemiology of sepsis. Intensive Care Med. 2004. 30. 5 27 -9

МАТЕРИНСКИЙ СЕПСИС • МКБ 10 085 Послеродовый сепсис- послеродовый эндометрит, лихорадка, перитонит, септицемия Шестая по значимости среди причин болезней женщин в возрасте 15 -44 лет – после: • депрессии, ВИЧ / СПИДа, туберкулеза, абортов и шизофрении. • Ежегодно 5, 2 миллиона новых случаев материнского сепсиса из них 62000 умирают Частота 0, 6 -1, 0 на 1000 родов • МС в развитых странах – 2, 1%, Латин. Америке – 7, 7%, Африке. Азии – 9, 7% и 11, 6%, 33% в развивающихся странах

ФАКТОРЫ РИСКА РАЗВИТИЯ СЕПСИСА ВО ВРЕМЯ БЕРЕМЕННОСТИ: • ожирение; • нарушение толерантности к глюкозе/сахарный диабет; • нарушения иммунитета/прием иммунодепрессантов; • анемия; • влагалищные выделения- вагинозы; • инфекции органов малого таза в анамнезе; • наличие в анамнезе инфекции, вызванной стрептококком группы В; • амниоцентез и другие инвазивные процедуры; • серкляж; • длительно существующий спонтанный разрыв плодных оболочек; • тесный контакт с лицами со стрептококковой инфекцией (членами семьи и т. п. ).

ФАКТОРЫ РИСКА РАЗВИТИЯ СЕПСИСА И СЕПТИЧЕСКОГО ШОКА В АКУШЕРСТВЕ -низкий социально-экономический статус -внебольничный, инфицированный аборт; — иммунодефицитное состояние; — хронические очаги инфекции (урогенитальный тракт), бронхолегочные заболевания, — сахарный диабет; — преждевременные роды; — кровопотеря, геморрагический шок (предлежание лаценты, отслойка плаценты); — внутриматочные манипуляции; — анемия; — преэклампсия и эклампсия - операция кесарево сечения. -

ФАКТОРЫ РИСКА СЕПСИСА ПОСЛЕ КЕСАРЕВО СЕЧЕНИЯ Ø воспалительный акушерский и гинекологический анамнез; Øпредшествующее бесплодие; Øперенесенные или имеющиеся хронические заболевания бронхолегочной системы; Øпредлежание плаценты в области разреза на матке; Øпроведение операции в условиях резкого истончения нижнего маточного сегмента; ØПатологическая кровопотеря, геморрагический шок; Øналичие технических погрешностей в процессе операции (методика Гусакова, грубые ручные приемы выведения головки, погрешности при ушивании матки). Краснопольский В, И. 2010 г

ЭТИОЛОГИЯ СЕПСИСА 1. 2. 3. Грам-отрицательная инфекция – 38% Грам-положительная инфекция – 37% Грибковая инфекция – 10% 4. Любой возбудитель может быть причиной развития сепсиса, включая грибы и риккетсии. В акушерском сепсисе: 1. • Грамположительная флора (энтерококк, стафилококки, стрептококки) 2. • Грамотрицательная флора (кишечная группа бактерий) 3. • Неспорообразующие анаэробы (бактероиды, пептококки, пептострептококки, фузобактерии)

ОСОБЕННОСТИ СОВРЕМЕННОГО СЕПСИСА Нарушение соотношения провоспалительных и противовоспалительных цитокинов с преобладанием последних – особенность сепсиса. главная патогенеза

НОВЫЕ ДАННЫЕ ПАТОГЕНЕЗА СЕПСИСА Тяжелый сепсис – это генетически детерминированный процесс. При генетическом анализе можно предсказать исход сепсиса у больного. 1) Точечная мутация генов, регулирующих экспрессию рецепторов врождённого иммунитета TLR, которые активирует Т-лимфоциты. 2) Полиморфизм цитокиновых генов определяет уровень провоспалительных и противовоспалительных цитокинов и, т. о. , гиперчувствительность к инфекции. Летальный исход при сепсисе определяет накопление противовоспалительных цитокинов (прежде всего IL-6) и дефицит провоспалительных цитокинов

НОВЫЕ ДАННЫЕ ПАТОГЕНЕЗА СЕПСИСА 3) Резкая активация процессов апоптоза – ускоренная гибель клеток. При этом селективный апоптоз CD-4, Влимфоцитов и макрофагов ведёт к параличу иммунитета. 4) Состояние «оглушения» клеток. Клетки морфологически не изменены, но они неспособны осуществлять свой функции. Это причина надпочечниковой, сердечной, печёночной недостаточности. Доказательство: только у 3 из 20 больных имеется очаговый некроз гепатоцитов при септическом шоке.

СОВРЕМЕННЫЕ МЕХАНИЗМЫ РАЗВИТИЯ ВАЗОДИЛАТАЦИОННОГО ШОКА 1. Открытие калий-АТФ-азных каналов. В клетках накапливается калий, что вызывает гиперполяризацию мембран, закрытие кальциевых каналов и рефрактерную ваэодилатацию. 2. Дефицит аргинин-ваэопрессина. Уровень вазопрессина в плазме снижается до 3 нг/л , что является одной из причин рефрактерной вазодилатации. 3. Активация (inducible) i. NO-синтетазы с массивным освобождением оксида азота (N 0). INOS активируется под действием провоспалительных цитокинов на макрофаги с продукцией большого количества оксида азота, который способствует глубокой вазодилатации с развитием недостаточности миокарда Landry D. W. //NEJM. – 2001. – Vol. 345. P. 588 -595

После восполнения внутрисосудистого объема и восстановления перфузии органов и тканей развиваются вторичные повреждения клеток, вызываемые уже реперфузией с образованием большого количества свободных кислородных радикалов, в частности супероксида, который, связываясь с N 0, образует пероксинитрит — еще один фактор синитрит повреждения мембран клеток.

MSIR — MATERNAL SYSTEMIC INFLAMMATORY RESPONSE - феномен физиологической готовности к ССВО — увеличение количества лейкоцитов; — увеличение уровня продуктов деградации фибрина/ (Dдимер); — дисфункция и повышенная проницаемость эндотелия сосудов; — снижение уровня физиологических антикоагулянтов (антитромбина III, протеина С, протеина S) — рост уровня провоспалительных цитокинов во время беременности и родов ССВО –развитие при осложнениях беременности (преэклампсия, преждевременные роды)

АКУШЕРСКИЙ СЕПСИС ВОЗНИКАЕТ • вследствие попадания инфекции в матку в процессе родов или в послеродовом периоде; • инфицировании остатков плацентарной ткани и сгустков крови; • наличии хронических или острых экстрагенитальных воспалительных заболеваний во время беременности и в родах; • инфицировании во время родового акта (затяжные роды, безводный длительный промежуток, родовой травматизм, задержка частей последа в матке, перитонит после кесарева сечения) • при локализации первичного гнойновоспалительного процесса в почках, молочных железах, абсцессы промежности, постинъекционный абсцесс.


КРИТЕРИИ ТЯЖЕЛОЙ ИНФЕКЦИИ СОГЛАСНО КОНФЕРЕНЦИИ СОГЛАСИЯ AMERICAN COLLEGE OF CHEST PHYSICIANS (ACCP) (1992) Синдром системного воспалительного ответа (ССВО)(Systemic Inflammatory Response ответа Syndrom – SIRS) Два или более признака из следующих: 1) Количество лейкоцитов в крови > 12, 000 или < 4, 000 в 1 мкл; либо относительное количество незрелых форм более 10 % 2) Частота сердечных сокращений > 90 ударов в минуту; 3) Частота дыхания > 20 дыханий в минуту; 4) Температура тела > 38° или < 36° C. Сепсис Системный воспалительный ответ на достоверно выявленную инфекцию при отсутствии других возможных причин подобных нарушений, которые характерны для SIRS Тяжелый сепсис Сепсис, который сопровождается дисфункцией органов, гипоперфузией или гипотезией. Гипоперфузия включает, но не ограничивается лактат-ацидозом, олигурией, либо нарушением сознания. Септический шок. Это осложнения тяжелого сепсиса и определяется как: сепсис – индуцированная гипотензия, неподдающаяся коррекции адекватным восполнением жидкости; перфузионные нарушения, которые могут включать (но не ограничиваться лишь ними) ацидоз, олигоурию или острое нарушение психического статуса. Пациенты, которые получают инотропные препараты или вазопрессоры могут не иметь гипотензии, но тем не менее сохраняют признаки гипоперфузионных нарушений и дисфункции органов, которые относят к проявлениям септического шока.

КЛАССИФИКАЦИЯ СЕПСИСА (ПО BONE, 1994) Синдром системного воспалительного ответа (ССВО) (наличие 2 или более приведенных признаков) • Температура тела > 38° или < 36° C. • Частота сердечных сокращений (ЧСС) более 90 в мин. • Частота дыхания )ЧД) более 20 в мин. • Рa. CO 2 (ниже 32 мм рт. ст. ) • Лейкоциты крови более 12000 или менее 4000, незрелых форм более 10% Сепсис – наличие очага инфекта и двух или более признаков ССВО Тяжелый сепсис – сепсис +полиорганная недостаточность Нарушение тканевой перфузии, олигоурия, энцефалопатия , увеличение уровня лактата в крови

КЛАССИФИКАЦИЯ СЕПСИСА Септический шок Сепсис с артериальной гипотензией, развивающейся, несмотря на адекватную инфузионную терапию, и нарушениями тканевой перфузии. У пациентов, находящихся на инотропной поддержке, гипотонии может и не быть, в то время, когда регистрируются нарушения перфузии Гипотензия Систолическое давление менее 90 мм рт. ст. или снижение более 40 мм рт. ст. от среднего в отсутствие других причин для гипотензии

SIRS Грамнегативные бактерии (эндотоксин) Нейтрофилы Моноциты/ макрофаги Грампозитивные бактерии (экзотоксины) Т-хелперы 1 типа Провоспалительные цитокины: ФНО- , ИЛ-12, ИЛ-6, ИЛ-8, ИФН- , ИЛ-2 ВОСПАЛЕНИЕ Локальное : антибактериальный ответ Системное : повреждение тканей органная недостаточность

СИНДРОМ КОМПЕНСАТОРНОГО ПРОТИВОВОСПАЛИТЕЛЬНОГО ОТВЕТА (CARS - COMPENSATORY ANTI-INFLAMMATORY RESPONSE SYNDROME) Бактериальный патоген Противовоспалительные медиаторы: Провоспалительные и Th 1 цитокины: ФНО- , ИЛ-12, ИЛ-6, ИЛ-8, ИФН- , ИЛ-2 + _ w Противовоспалительные цитокины (ИЛ-10, ИЛ-4, ТРФ- ) w Растворимые ингибиторы (ФНО- R, ИЛ-1 RA) w Глюкокортикоиды, простагландин Е 2 Системное воспаление _

Тяжесть патологического процесса при сепсисе чаще в большей степени зависит от интенсивности ответа организма на повреждение, чем от прямого повреждающего эффекта самой инфекции. Тяжелый сепсис и септический шок возникают у пациенток с чрезмерным или плохо контролируемым иммунным ответом организма, который проявляется генерализованной воспалительной реакцией.

ПО КЛИНИЧЕСКОМУ ТЕЧЕНИЮ РАЗЛИЧАЮТ: молниеносный сепсис (клиническая молниеносный картина развивается в течение 1 -3 суток, он наблюдается у 2% больных); острый, наблюдается у 40% больных в острый, течение 5 -7 суток; подострый - длится 7 -14 суток, его частота составляет 50 -60%; хронический (хрониосепсис) – 3 и более месяца рецидивирующий Герасимов Г. И. Проблемы беременности (2002), № 3, 24 - 29:

ДИАГНОСТИЧЕСКИЕ КРИТЕРИИ СЕПСИСА (2014 - SURVIVING SEPSIS COMPAIGN) Общие изменения: ØЛихорадка - температура более 38, 3 ºС ØГипотермия <36 ºС ØТахикардия более 90 уд/мин ØТахипное более 20 в мин. ØНарушение писхического состояния – энцефалопатия ØПоявление отеков при положительном водном балансе (>20 мл/кг/24 часа) ØГипергликемия (уровень глюкозы в плазме >140 мг/дл или >7, 7 ммоль/л при отсутствии диабета)

ДИАГНОСТИЧЕСКИЕ КРИТЕРИИ СЕПСИСА (2014 - SURVIVING SEPSIS COMPAIGN) Воспалительные изменения ØЛейкоцитоз более 12000 /л ØЛекопения менее 4000 /л ØНормальное количество лейкоцитов с незрелыми формами более 10% ØС-реактивный белок сыворотки крови более 2 стандартных отклонений от нормы ØПрокальцитонин плазмы крови увеличен в 2 раза (при бактериальной инфекции повышается концентрация ПКТ в крови - маркер бактериальных инфекций) ØПри тяжелых бактериальных инфекциях ПКТ может возрастать от 20 до 200 нг/мл.

ДИАГНОСТИЧЕСКИЕ КРИТЕРИИ СЕПСИСА (2014 - SURVIVING SEPSIS COMPAIGN) Гемодинамические нарушения ØАртериальная гипотензия (САД <90 мм. рт. ст. , среднее АД <70 мм. рт. ст. (снижение АД более чем на 40 мм рт. ст. ) Показатели дисфункции органов ØАртериальная гипоксемия Ра. О 2 (парциальное давление кислорода в артериальной крови) /FIO 2(фракция кислорода во вдыхаемом воздухе) <33, 2 к. ПА ØОстрая олигоурия (менее 0, 5 мл/кг/час) в течение 2 часов адекватного лечения ØПовышение уровня креатинина >44, 2 мкмоль/л или >176 мкомль/л ØНарушение коагуляции – МНО >1, 5, АЧТВ >60 сек, тромбоцитопения - <100 000/л ØГипербилирубинемия (общий билирубин плазмы >70 мкмоль/л) ØКишечная непроходимость (илеус) Показатель тканевой перфузии Ø повышение уровня сывороточного лактата более 1 ммоль/л Ø снижение наполнения капилляров, пятнистость, сыпь

ПРОГРЕССИРУЮШИЕ ПРИЗНАКИ СЕПСИСА § Лихорадка или озноб более 39ºС § Диарея и рвота (могут указывать на продуцирование экзотоксинов- начало септического шока) § Сыпь (генерализованная стрептококковая макулопапулезная сыпь или фульминантная пурпура) § Абдоминальная /тазовая тянущая боль § Выделение из влагалища (неприятный запах – анаэробная инфекция, серозно-кровянистый характер – стрептококковая инфекция) § Продуктивный кашель § Симптомы поражения мочевых путей

ПРОГЕССИРУЮЩИЕ ПРИЗНАКИ СЕПСИСА Проявления интоксикации: Ø Сильные головные боли, головокружение, упадок сил; Ø Рвота, отсутствие аппетита; Ø Бессонница, возбуждение, некритичность; Ø Потеря сознания, бред, коматозное состояние. Ø • Гепато- и спленомегалия. Ø • Геморрагическая сыпь: Расстройства микроциркуляции →Развитие распространенного васкулита→ Микротромбозы сосудов. • Острый гастроэнтерит (возможны ишемические поражения печени и кишечника).

КЛИНИКО-ЛАБОРАТОРНАЯ ДИАГНОСТИКА СЕПСИСА Микробиологическое исследование крови, раневого отделяемого, мочи, мокроты, ликвора и экссудата брюшной полости в зависимости от локализации Идентификация микроорганизмов и их количественная оценка. Оценку органных расстройств и их тяжесть целесообразно выполнять по шкалам SOFA или MODS, имеющих высокую информационную ценность при минимуме составляющих клиниколабораторных параметров Рекомендации по классификации, диагностике, профилактике и лечению сепсиса. Комитет экспертов (2002)

ДИАГНОСТИКА СЕПСИСА. ПРАВИЛА ЗАБОРА КРОВИ ДЛЯ БАКТЕРИОЛОГИЧЕСКОГО ИССЛЕДОВАНИЯ Забирать кровь для исследования до назначения антибиотиков, или перед очередным введением препарата • Забирать кровь из двух или трех разных вен (правая, левая рука) с интервалом 30 минут. • Не допускать забор крови из катетера. При выделении St. aureus, Klebsiella pn. , Pseudomonas aeruginosa, грибов – одна положительная гемокультура

ОСНОВНЫЕ ПРИНЦИПЫ Основополагающие ИНТЕНСИВНОЙ ТЕРАПИИ СЕПТИЧЕСКОГО ШОКА принципы лечения сепсиса • • • Немедленная госпитализация больной в отделение интенсивной терапии. Коррекция гемодинамических нарушений путем проведения инотропной терапии и адекватной инфузионной терапии под постоянным мониторингом гемодинамических показателей Поддержание адекватной вентиляции и газообмена. Нормализация функции кишечника и раннее энтеральное питание. Своевременная коррекция метаболизма под постоянным лабораторным контролем. Рациональная антибактериальная терапия под постоянным микробиологическим контролем. До начала антибиотикотерапии необходимо, как минимум, 2 посева. • • Иммуномодулирующая и антимедиаторная терапия. Хирургическая санация очага инфекции

SURVIVING SEPSIS – START SEPSIS SIX PLUS TWO (2013) 1. Кислород – через кислородную маску (сатурация >94%) 2. Культура крови (забор крови перед введением антибиотиков) 3. Определение лактата крови (опасно, если более 2 ммоль/л- органная дисфункция), определение гемоглобина (менее 80 мг/л) 4. Введение антибиотиков (1 дозу в 1 час) 5. Инфузионная терапия (если гипотензия – болюсно 0, 9% физиологический раствор до 60 мл/г. Если тяжелая преэклампсия – мониторинг. 6. Катетеризация мочевого пузыря Плюс 2: 1. Решение вопроса о родоразрешении или операции 2. Профилактика тромбоэмболии

ПРИОРИТЕТНЫЕ НАПРАВЛЕНИЯ ЛЕЧЕНИЯ БОЛЬНЫХ С ТЯЖЕЛЫМ СЕПСИСОМ 1) хирургическая санация инфекционного очага; 2) адекватная и ранняя антибиотикотерапия; 3) адекватная респираторная поддержка; 4) фармакологическая сосудистая и инотропная поддержка; 5) управляемая гипокоагуляция; 6) коррекция гиповолемии; 7) нутриентная поддержка; 8) иммуноориентированная терапия, 9) эфферентные методы терапии.

ВОПРОС ОБ УДАЛЕНИИ МАТКИ ДОЛЖЕН БЫТЬ ПОСТАВЛЕН ПЕРЕД КОНСИЛИУМОМ ВРАЧЕЙ В СЛЕДУЮЩИХ СЛУЧАЯХ Помимо матки, не выявлено других очагов инфекции, обусловливающих тяжесть состояния. Ø Маточное кровотечение на фоне сепсиса; Ø • Перфорация матки, гнойно-некротически эндометрит, некроз шва на матке после операции КС ØГнойные образования в области придатков матки; ØНарастание воспалительной реакции на фоне проводимой терапии (консервативная терапия неэффективна). ØРост прокальцитонинового теста и увеличение СРБ Ø Антенатальная гибель плода на фоне инфекционного процесса любой локализации. Ø Признаки начинающейся и/или прогрессирующей полиорганной недостаточности

АНТИБАКТЕРИАЛЬНАЯ ТЕРАПИЯ До начала антибиотикотерапии получить не менее 2 х посевов В/в а/б терапия должна начинаться в течении первого часа с момента распознавания тяжелого сепсиса после получения соответствующих культур Начало а/б терапии 1 или > 1 препаратом действующим на предпологаемый источник При выборе препаратов следует руководствоваться моделями восприимчивости в данном сообществе, больнице. Антибактериальный режим следует переоценивать через 48 -72 часа.

Рациональная антибиотикотерапия 1. Бактериоскопия (Грам (+), Грам (-) кокки, палочки, отсутствие флоры) 2. Бактериальный посев с определением чувствительности к антибактериальным препаратам

Принцип диско- диффузионного метода определения чувствительности. Нет зоны подавления роста микроорганизма вокруг диска с антибиотиком: Микроорганизм резистентен к антибиотику (3) 1 3 2 Зона подавления микроорганизма вокруг диска с антибиотиком: Микроорганизм чувствителен к антибиотику (1) Или умеренно резистентен к нему (2)
Экспресс метод определения микробиологической чувствительности 24 ч.

Принципы антибиотикотерапии Карбопенемы Цефалоспорины IV Аминогликозиды Цефалоспорины І - ІІІ Эмпирический де-эскалационный Карбопенемы Фторхинолоны Цефалоспорины (МАКСИПИМ) IV ПО ЧУВСТВИТЕЛЬНОСТИ Фторхинолоны ИЛИ Гентамицин Аминогликозиды Ампициллин Цефалоспорины I- III Ампициллин Пенициллин Эмпирический эскалационный РАЦИОНАЛЬНО Пенициллин
![«Золотой стандарт» антибиотикотерапии при абдоминальном сепсисе Имипенем [при гр (+)] Карбопенемы Фторхинолоны Меропенем «Золотой стандарт» антибиотикотерапии при абдоминальном сепсисе Имипенем [при гр (+)] Карбопенемы Фторхинолоны Меропенем](https://present5.com/presentation/13356803_441354286/image-39.jpg)
«Золотой стандарт» антибиотикотерапии при абдоминальном сепсисе Имипенем [при гр (+)] Карбопенемы Фторхинолоны Меропенем [при гр (-)] Цефалоспорины IV Моксифлоксацин Ципрофлоксацин цефепим (максипим) Цефалоспорины III цефоперазон цефтриаксон Аминогликозиды цефтазидим амикацин Антианоэробные препараты метранидазол клиндамицин

ПРИНЦИПЫ АНТИБИОТИКОТЕРАПИИ ПРИНЦИП ДЕКОНТАМИНАЦИИ ТЯЖЕЛЫЙ СЕПСИС При тяжелом сепсисе и СШ Комбинация первые 30– 60 мин после антибиотиков, постановки диагноза обладающих активностью необходимо внутривенно в отношении ввести потенциальных антибактериальные возбудителей (2 -3) препараты —за каждый Внутривенный путь час задержки начала введения антибактериальной Выбор адекватной дозы и терапии выживаемость кратности введения снижается на 7, 7%.

ПРИНЦИПЫ ЛЕЧЕНИЕ СЕПСИСА 1. Инфузионная терапия 8. Седация, анальгезия, 2. Вазопрессоры 3. Инотропная терапия 4. Кортикостероиды 5. Продукты крови 6. Иммуноглобулины 7. Поддержка дыхательной функции нейромускулярная блокада 9. Контроль глюкозы 10. Гемодиализ 11. Бикарбонатная терапия 12. Профилактика тромбоза глубоких вен 13. Противоязвенная терапия (стрессовые язвы) 14. Питание 15. Уход 16. Контроль глюкозы

ПРОГРАММА ИНФУЗИОННОЙ ТЕРАПИИ ØСначала жидкость вводят со скоростью 20 – 30 мл/мин. на протяжении 15 -20 мин, а потом - в обычном темпе, в зависимости от показателей гемодинамики, дыхания, диуреза и др. ØДля инфузии применяют производные гидроксиэтилкрахмала (рефортан, стабизол) и кристаллоиды (0, 9% раствор хлорида натрия, раствор Рингера). ØОптимальное соотношение кристаллоидов и производных гидроксиэтилкрахмала должно составлять 2: 1. Ø В большинстве случаев требуется проводить массивные инфузии кристаллоидных и коллоидных растворов, часто до 4 -6 л в первые сутки.

ПРОГРАММА ИНФУЗИОННОЙ ТЕРАПИИ В отличие от других коллоидов растворы гидроксиэтилкрахмала уменьшают степень повреждения эндотелия капилляров, улучшают функцию легких и уменьшают проявления системной воспалительной реакции J. Boldt et al. , Intensive Care Med 24 (1998) 28 -36

Влияние ГЭК на ретикуло-эндотелиальную систему Купферовские клетки печени Моноциты крови Перитонеальные макрофаги Микроглия Макрофаги селезёнки Способность к фагоцитозу Туморнекротический фактор и интерлейкины антигены адгезии E-селектин, ICAM-1 Клубочковый мезангиум Макрофаги лимфоузлов Альвеолярные макрофаги

ПРОГРАММА ИНФУЗИОННОЙ ТЕРАПИИ ГЭК при сепсисе оказывают протекторный эффект на эндотелий сосудов, способствуя нормализации проницаемости и сохранению жидкости в сосудистом русле. Предполагают положительное воздействие растворов ГЭК на воспалительный ответ и проницаемость эндотелия вследствие уменьшения освобождения адгезивных молекул, улучшения спланхнической перфузии, что способствует восстановлению кишечного барьера. Глумчер Ф. С. Мистецтво лікування (2004). - № 8. – С. 4 – 9.

ПРОГРАММА ИНФУЗИОННОЙ ТЕРАПИИ Метанализ рандомизированных исследований доказал, что применение 5% альбумина при 5% альбумина критических состояниях оказывает содействие повышению летальности больных. Cochrane Injuries Group// BMJ, 1998, v. 317, p. 235 -240.

ИНОТРОПНАЯ ПОДДЕРЖКА СИМПАТОМИМЕТИКИ Препаратом выбора является допамин в допамин дозе 5 -10 мкг/кг/мин (максимум до 20 мкг/кг/мин) или добутамин, который вводится с скоростью 5 -40 мкг/кг/мин. Если эта терапия не приводит к стойкому повышению АД, то симпатомиметическую терапию необходимо дополнить введением норадреналина гидротартрата с скоростью норадреналина гидротартрата 0, 1 -0, 5 мг/кг/мин одновременно снижая дозу допамина до 2 -4 мкг/кг/мин Sakka S. G. at al. , British Journal of Anesthesia, 2000, Vol. 84, N 6, 758 -762.

ИНФУЗИЯ АРГИНИНАВАЗОПРЕССИНА ØПрименение аргинина-вазопрессина в низких дозах (< 0, 04 ЕД/мин) может с спобствовать нормализации гормонального статуса и стабилизации функции сердечнососудистой системы. ØПротивопоказано его введение при кардиогенном шоке и не восполненной гиповолемии. ØИзбыточные дозы АВ вызывют генерализованную вазоконстрикцию, усиливают ишемию органов и тканей, в том числе миокарда и кишечника.

АНТАГОНИСТЫ ОПИАТОВ Учитывая роль бета-ендорфинов в патогенезе септического шока оправданно одновременное применение с симпатомиметиками налоксона до 2, 0 налоксона мг, что оказывает содействие повышению АД Boeuf B. at al. , The Cochrane Library, Issue 4, 2003. Chichester, UK: John Wiley & Sons, Ltd.

ГЛЮКОКОРТИКОИДЫ Эффективность глюкокортикостероидов при проведении интенсивной терапии септического шока в настоящее время не доказана. Хотя не исключается их положительное влияние на биологические мембраны. Так, в литературных источниках существуют ссылки на уменьшение продукции NO под их влиянием. Поэтому при неэффективности комплексной гемодинамической терапии возможно их применение. Эквивалентной дозой считается 200 - 300 мг/сут (в перерасчете на гидрокортизон) в течение 5 – 7 сут. Для профилактики эрозивних повреждений желудка его введения необходимо комбинировать с блокаторами Н 2 рецепторов (ранитидин, квамател). Sprung C. L. , Caralis P. V. , Marcial W. R. et al. . N. Engl. J. Med. 1994; 311: 1137 -1143.

ОКСИГЕНОТЕРАПИЯ До 85% пациентов с СШ нуждаются в респираторной поддержке в течение 1 – 2 недель Для коррекции гипоксемии необходима оксигенотерапия, в тяжелых случаях – ИВЛ. Sp. O 2 не меньше 90%

НОРМАЛИЗАЦИЯ ФУНКЦИИ КИШЕЧНИКА И РАННЕЕ ЭНТЕРАЛЬНОЕ ПИТАНИЕ ØЭнтеральное капельное введение 0, 9% раствора хлорида натрия или негазированной минеральной воды 400 – 500 мл в сутки через желудочный зонд, или ниппельный дуоденальный зонд с дальнейшим увеличением объема введенной жидкости и расширением пищевых препаратов, при нормализации перистальтики в режиме „алиментарного фактора”, что отвечает 2000 – 4000 ккал в сутки. Ø Целесообразно также одновременное применение прокинетиков (метоклопрамид) и глутаминовой кислоты, поскольку последняя нормализует обмен веществ в ворсинках кишечника. ØНежелательно энтеральное введение глюкозы.

ПРЕИМУЩЕСТВА ЭП Протекция слизистой оболочки и сохранение барьерной функции кишечника Физиологический путь поступления пищи с более адекватной продукцией гормонов в ЖКТ Отсутствие в необходимости длительных катетеризаций вен и массивных в/в инфузий, что также снижает риск инфекционных осложнений Возможность обеспечения более эффективной нутриционной поддержки Меньший риск образования язв желудка и кишечника Меньшая стоимость Противопоказания к ЭП - Гемодинамическая нестабильность Внутрибрюшные осложнения после абдоминальных операций (несостоятельность кишечных анастомозов и др. )

СЕЛЕКТИВНАЯ ДЕКОНТАМИНАЦИЯ КИШЕЧНИКА После стабилизации состояния больной для дальнейшей профилактики бактериальной транслокации возможно проведение селективной деконтаминации кишечника: 4 раза в сутки в кишечник вводят смесь полимиксина – 100 мг, тобрамицина – 80 мг и амфотерицина – 500 мг

КОРРЕКЦИЯ ИММУННЫХ НАРУШЕНИЙ Ø Иммуноглобулины в/в: пентаглобин по 5 мл/кг/сут, интраглобин - 2 -5 мл/кг 2 -3 дня, габриглобин. Ø предотвращение чрезмерной стимуляции макрофагов снижение воспалительной активности моноцитов/макрофагов и нейтрофилов Ø • Ронколейкин в/в 1 -4 инфузии по 0, 5 мг через 48 часов, при отсутствии эффекта - повторные курсы по 2 инфузии в дозе 1, 0 мг через 48 часов. ØПоказания : лимфопения <1400 ( абс. число).

ИММУНОМОДУЛИРУЮЩАЯ И АНТИМЕДИАТОРНАЯ ТЕРАПИЯ Существуют убедительные доказательства внутривенного применения моноклональных иммуноглобулинов в сочетании с пентоксифиллином (тренталом). Учитывая отсутствие в Украине моноклональных иммуноглобулинов целесообразно применение пентоксифиллина в комплексной терапии септического шока и сепсиса. С этой же целью оправданно назначение дипиридамола (курантила). De Schryver E. L. L. M. , Algra A. , van Gijn J. The Cochrane Library, Issue 4, 2003. Chichester, UK: John Wiley & Sons, Ltd.

ЭФФЕРЕНТНЫЕ МЕТОДЫ ЛЕЧЕНИЯ СЕПСИСА 1. Дискретный плазмаферез 2. Гемосорбция, лимфосорбция 3. Гемодиализ (остаточный азот повышен более, чем 2 раза, К - до 7 экв/л, креатинин - 1500 мг/л, мочевина более 1, 5 г/л)

МЕТОДЫ ЭКСТРАКОРПОРАЛЬНОЙ ДЕТОКСИКАЦИИ Применение методов экстракорпоральной детоксикации возможно после стабилизации состояния пациентки. Имеются данные, что применение этих методов при развернутой картине полиорганной недостаточности повышает летальность больных Wicher J. , Bienvenu J. , Monneret G. Ann. Clin. Biochem. 2001; 38: 459 – 462.

ДИАГНОСТИКА СЕПТИЧЕСКОГО ШОКА Диагноз септического шока устанавливается, если к выше перечисленным клинико-лабораторным признакам присоединяются: 1. Артериальная гипотензия (систолическое давление меньше 90 мм рт. ст. или снижение больше чем на 40 мм рт. ст. от исходного уровня) 2. Тахикардия более 100 уд/мин. ; 3. Тахипное более 25 за минуту; 4. Нарушение сознания (меньше 13 баллов по шкале Глазго); 5. Олигурия (диурез меньше 30 мл/ч); 6. Гипоксемия (Ра. О 2 меньше 75 мм рт. ст. при дыхании атмосферным воздухом); 7. Sp. О 2 < 90%; 8. Повышение уровня лактата более 1, 8 ммоль/л (при уровне лактатa > 8, 0 ммоль/л – прогноз крайне неблагоприятный (летальность – 95%)) 9. Петехиальная сыпь, некроз участков кожи.

ДЛЯ СВОЕВРЕМЕННОЙ ДИАГНОСТИКИ СЕПТИЧЕСКОГО ШОКА НЕОБХОДИМО ПРОВОДИТЬ СЛЕДУЮЩИЕ МЕРОПРИЯТИЯ: Ø мониторинг параметров гемодинамики: артериального давления, частоты сердечных сокращений, центрального венозного давления; ЕКГ Ø контроль параметров дыхательной системы (подсчет частоты дыхания, газы крови, Sp. О 2); Ø почасовый контроль диуреза; Ø измерение ректальной температуры минимум 4 раза в сутки для сопоставления с температурой тела в подмышечной впадине; Ø посевы мочи и крови (дважды в сутки) и выявление возбудителя в канале шейки матки; Ø определение кислотно–щелочного состояния крови и насыщение тканей кислородом; Ø подсчет количества тромбоцитов и определение содержимого фибриногена и мономеров фибрина (растворимый фибрин).

КЛИНИЧЕСКАЯ КАРТИНА КРОВИ Анемия встречается во всех случаях, содержимое гемоглобина у 45% больных < 80 г/л Нейтрофильный лейкоцитоз со сдвигом лейкоцитарной формулы влево. В отдельных случаях может отмечаться лейкемоидная реакция с количеством лейкоцитов до 50 – 100 тыс. и выше. Морфологические изменения нейтрофилов включают токсичную зернистость, появление телец Доле и вакуолизацию. Тромбоцитопения при сепсисе встречается в 56% случаев, лимфопения – в 81, 2%

КЛИНИЧЕСКАЯ КАРТИНА КРОВИ Степень интоксикации отображает лейкоцитарный индекс интоксикации (ЛИИ), который рассчитывают по формуле: ЛИИ = (С +2 П + 3 Ю + 4 Ми)(Пл – 1) (Мо + Ли)(Э + 1) где С – сегментоядерные нейтрофилы, П – палочкоядерные лейкоциты, Ю – юные лейкоциты, Ми – миелоциты, Пл – плазматические клетки, Мо – моноциты, Ли – лимфоциты, Э – эозинофилы. В норме ЛИИ = 1. Повышение индекса до 2 -3 свидетельствует об ограниченном воспалительном процессе, повышение до 4 -9 – о значител ьном бактериальном компоненте эндогенной интоксикации Лейкопения с высоким ЛИИ является плохим прогностическим признаком для пациенток с септическим шоком

СЕПСИС ИНДУЦИРОВАННАЯ ГИПОТОНИЯ – СЕПТИЧЕСКИЙ ШОК • снижение систолического АД до уровня ниже 90 мм рт. ст. у «нормотоников» или на 40 мм рт. ст. и более от «рабочего» АД у лиц с артериальной гипертензией при отсутствии других причин. Гипотония устраняется в короткий срок с помощью инфузионных препаратов в дозе 15— 20 мл/кг. • Септический шок — тяжелый сепсис с тканевой и органной гипоперфузией, артериальной гипотонией: • — систолическое АД ниже 90 мм рт. ст. ; • — среднее АД ниже 65 мм рт. ст. ; • — артериальная гипотония сохраняется после введения инфузионных растворов — 20— 40 мл/кг. • Для коррекции требует применения вазопрессоров и инотропной поддержки

РЕФРАКТЕРНЫЙ СЕПТИЧЕСКИЙ ШОК • артериальная гипотония, несмотря на адекватную инфузионную терапию и применение инотропной и сосудистой поддержки. • Общие параметры: — температура выше 38, 3°С или ниже 36°С; • — ЧСС более 90 в минуту — тахипноэ (ЧД> 20 в минуту); • — измененный психический статус. • Воспалительные показатели: • — лейкоцитарная формула более 12 000 в мкл, менее 4 000 в мкл или более 10% незрелых форм; • — С-реактивный белок в плазме более чем в 2 раза выше нормы; • — прокальцитонин в плазме более чем в 2 раза выше нормы.

ЛЕЧЕНИЕ СШ Своевременное начало и адекватность начальной терапии септического шока в акушерстве определяют исход заболевания в целом. Начальная терапия тяжелого сепсиса и септического шока: • — стабилизация гемодинамики (инфузия, вазопрессоры и инотропные препараты); • — антибактериальная терапия; • — адъювантная терапия (компоненты крови, кортикостероиды, рекомбинантный активированный протеин С ).

ОБЩИЕ МЕРОПРИЯТИЯ ПРИ ТЯЖЕЛОМ СЕПСИСЕ И СЕПТИЧЕСКОМ ШОКЕ При установлении диагноза тяжелого сепсиса или септического шока терапию необходимо начинать еще до поступления больной в реанимацию! • Первые 30 мин: • 1. Венозный доступ (периферическая и центральная вена). • 2. Оценка АД, ЧСС, сатурации кислорода и диуреза. • 3. Взятие посевов крови и других сред. Бактериологические посевы (дважды) должны быть взяты до начала антибиотикотерапии, но не должны ее задерживать. • 4. Лабораторное исследование: лейкоциты и лейкоцитарная формула, уровень прокальцитонина, количество тромбоцитов, АПТВ, MHO, кислотно-основное состояние и газы крови, уровень билирубина, ACT, АЛТ. Общий анализ мочи. • 5. Рентгенография легких

ОБЩИЕ МЕРОПРИЯТИЯ ПРИ ТЯЖЕЛОМ СЕПСИСЕ И СЕПТИЧЕСКОМ ШОКЕ Независимо от других условий в первые 30— 60 мин после постановки диагноза внутривенно ввести антибактериальные препараты. Начальная эмпирическая антибактериальная терапия включает один или более препаратов, активных в отношении всех вероятных инфекционных агентов (бактериальный и/или грибковый) Продолжительность терапии 7— 10 сут. • Эмпирическая терапия может включать в себя карбапенемы, цефалоспорины III—IV поколения в сочетании с левофлоксацином, нетромицином, кларитромицином. В дальнейшем могут применяться ванкомицин или линезолид

ИНФУЗИОННАЯ ТЕРАПИЯ кристаллоидами и/или синтетическими коллоидами. Преимущества одних растворов перед другими не установлены (уровень 1 В). • В первые 30 мин вводятся 1000 мл кристаллоидов (рингер, стерофундин) или 500 мл синтетических коллоидов (венофундин, гелофузин, тетраспан). Средний объем инфузии — 2000— 3500 мл/сут, но может быть и увеличен. • ЦВД должно быть выше 8 см вод. ст. , у пациентов, находящихся на искусственной вентиляции легких — выше 12 см вод. ст. Ограничение объема инфузии требуется, когда ЦВД или давление заклинивания легочной артерии (ДЗЛА) увеличивается без гемодинамической стабилизации (АД, ЧСС).

ПОСЛЕ ВЫПОЛНЕНИЯ МЕРОПРИЯТИЙ необходимо оценить: • 1. Ответ АД на введение инфузионных растворов 20 мл/кг в течение 30 мин: • при повышении среднего АД более 65 мм рт. ст. продолжить инфузионную терапию для достижения ЦВД более 8 см вод ст. (у пациентов на ИВЛ — более 12 см вод. ст. ). • При отсутствии эффекта подключить вазопрессоры внутривенно: цель — достичь среднего АД выше 65 мм рт ст. • Для стартовой терапии • норадреналин 2— 20 мкг/мин или допмин 5 — 20 мкг/кг/мин, а для дополнительной терапии— адреналин 1— 10 мкг/мин, мезатон 40— 300 мкг/мин или вазопрессин 0, 03 ЕД/мин. • Добутамин должен использоваться при миокардиальной дисфункции и повышении ДЗЛА— максимум 20 мкг/кг'/мин» .

ЛЕЧЕНИЕ СШ Последующие 6 ч: • необходимо как можно раньше (оптимально в первые 6 ч) решить главный вопрос в лечении сепсиса и септического шока—о своевременной и адекватной санации очага инфекции, . При этом вопрос о необходимости удаления матки должен стоять постоянно

В ПЕРВЫЕ 6 Ч ИНТЕНСИВНОЙ ДОЛЖНЫ БЫТЬ ДОСТИГНУТЫ СЛЕДУЮЩИЕ ПАРАМЕТРЫ ЦВД 8— 12 мм рт. ст. — за счет инфузионной терапии; • — среднее АД выше 65 мм рт. ст. — инфузионная терапия+ вазопрессоры; • — диурез более 0, 5 мл/кг/ч; • — насыщение кислорода в центральной вене (Scv 02) (верхняя полая вена) более 70% или в смешанной венозной крови (SO) более 65%. • Если при восстановлении ЦВД Scv 02 и Sv 02 не увеличиваются, то показаны переливание эритроцитов или инфузия добутамина

КОРТИКОСТЕРОИДЫ: v В ситуации, когда после проведения инфузионной терапии (20 мл/кг) и вазопрессоров и инотропных препаратов не происходит стабилизации гемодинамики, v подключаются только водорастворимый гидрокортизон внутривенно и только у взрослых в дозе не более 300 мг/сут v Кортикостероиды необходимо отменить, как только прекращается введение вазопрессоров. v Кортикостероиды не должны применяться при отсутствии клиники шока.

КОМПОНЕНТЫ КРОВИ Поддерживать уровень гемоглобина 70— 90 г/л • — свежезамороженная плазма в дозе не менее 15 мл/кг используется при наличии кровотечения и при инвазивных процедурах на фоне коагулопатии; • — свежезамороженная плазма не должна использоваться только для коррекции лабораторных изменений при отсутствии кровотечения или инвазивных процедур • — поддерживается количество тромбоцитов выше 50 000 в мкл. • Рекомбинантньгй активированный протеин С – дротрекогин альфа (пациенты с тяжелым сепсисом и высоким риском смерти, полиорганной недостаточностью), • — не рекомендуется применение rh. APC у пациентов с сепсисом и низким риском смерти, • — доза активированного протеина С 24 мкг/кг/ч в течение 96 ч.

КРИТЕРИИ НАЧАЛА РЕСПИРАТОРНОЙ ПОДДЕРЖКИ ПРИ ТЯЖЕЛОМ СЕПСИСЕ Отсутствие самостоятельного дыхания и патологические ритмы дыхания. 1. • 2. Нарушение проходимости верхних дыхательных путей. • 3. Снижение респираторного индекса менее 200 мм рт. ст. • 4. Септический шок.

ЛЕЧЕНИЕ СШ v Контроль уровня глюкозы в крови (внутривенный инсулин) — он должен поддерживаться на уровне менее 8, 3 ммоль/л (150 мг/дл). v Почечная заместительная терапия рекомендована при наличии почечной недостаточности, а постоянная гемофильтрация показана для регулирования водного баланса у пациентов с нестабильной гемодинамикой. v Профилактика тромбоза глубоких вен (низкая доза нефракционированного гепарина, профилактические v дозы низкомолекулярного гепарина — клексан 40 мг/сут, нефармакологические методы тромбопрофилактики)

ВАЖНО!!! Пациенткам с тяжелым сепсисом и септическим шоком медицинская помощь должна оказываться только в отделении реанимации и интенсивной терапии многопрофильного стационара, располагающего современными технологиями диагностики, мониторинга и интенсивной терапии (например, такими, как почечная заместительная терапия, неинвазивная ИВЛ и т. д. ).

СПАСИБО ЗА ВНИМАНИЕ!!!
Лекция для кур сантов сепсис (новая) 2014.pot.pptx